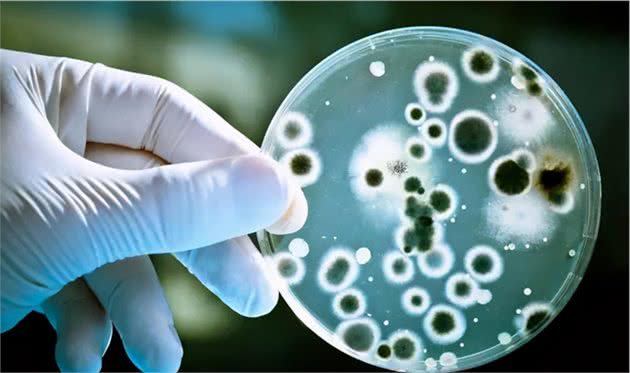

宠物碗竟然比马桶还脏1000倍?
一个隐藏的小细节
洗碗?不好意思,没注意过,可能哪天顺手就洗了吧~再说养宠物不是应该只关心吃什么喝什么吗?吃的好身体才健康,怎么现在还说到碗上了,养猫狗都需要精细成这个样子了?
大错特错
我们时常忽略了宠物食盆的清洁!据不完全统计不卫生的宠物碗会直接拉高导致黑下巴、腹泻、胃炎、肾衰竭等等疾病发生的概率。
不信?,我们来看令人毛骨悚然的数据:
公共卫生安全组织NSF International对常见家用品的细菌数量进行调查:
序号名称每10cm2微生物数1洗碗布/海绵321,629,8692牙刷架3,318,4773宠 物 碗 473,8284咖啡壶50,5855厨房水槽31,9056网球/宠物玩具29,3657水龙头把手28,0688台面5599浴室门把手31510炉灶旋钮278
宠物碗仅次于洗碗布和牙刷杯,在家庭单位细菌数量排名第三!网球/宠物玩具排名第六!
数据调查显示宠物碗每10平方厘米的细菌数量是473828个,大家认为很脏的马桶每10 平方厘米的细菌数量只有266个。也就是说,宠物碗比马桶还要脏一千多倍……

你还敢说,宠物只有“吃”最重要吗?宠物用品的清洁,环境的护理,同样不可小觑,而后者带来的危害甚至是致命的!
为什么会这么夸张?
因为家里的厕所其实是一上一冲的,宠物碗很少有主人每天清洗。食物残渣、水分和毛球的反复接触使其碗成为天然细菌培养皿。
再加上一些主人的懒惰,他们可能几天甚至一个月只清洗一次,这给了细菌一个良好的生长周期,导致宠物碗成为家里的第三个脏物。

曾经还有耳闻,主人生怕新来的小猫吃不好吃不习惯,甚至每天都把湿粮干粮一起放碗里混合着吃,是每天哦!小猫咪一顿又吃不了多少,这样导致喂食器里的食物迅速腐败变质,想想都让猫难以下咽。
事实上,宠物碗过脏会带来巨大健康问题1 猫黑下巴
毛囊炎是猫最常见的日常问题。许多黑下巴长期无法治愈。事实上,这与猫的饮食用具太脏直接相关。

2 口腔问题
不仅如此,不洁净的饮食用具也容易加重原有的口腔炎症。口腔炎的疼痛会影响食欲,还容易引起其他并发症。
若不能得到及时的治疗,还会有牙周炎、牙结石、口臭严重真的像粪坑的味道,狗狗尤其明显,严重了甚至需要拔掉满口牙齿。
保持宠物碗清洁,先挑材质!
事实上,保持宠物碗清洁并不难。我们可以从碗材料的选择开始。
陶瓷碗:
光滑容易清洗,加上陶瓷本身的重量不易被打翻,现在的陶瓷制品也越来越精致漂亮,高端大气上档次,配得上小猫咪高调的颜值。是个很不错的选择,不过一旦不小心打碎,一定要打扫干净,可别扎伤主子哦!
推荐指数:★★★★★
清洗频率:1天/次,用百洁布和洗涤精清洗,以下相同。

不锈钢碗:
优点是耐咬,不易破碎,缺点是不锈钢本身材料轻,容易翻转,所以选择底座稳定性高,有一点非常重要:易于清洁是王!
推荐指数:★★★☆☆
清洗频率:1顿/次,湿粮吃完就得立马清洗,以防细菌滋生。

豹米花专享不锈钢盆
自动喂食(饮水)机:
作为现代化产品的伟大发明,自动喂食机的研发成功的解放了一批家长,但带来便利的同时也带来了不少隐患。省去了添水添食的烦恼,就更容易遗忘清洗的问题。许多使用自动喂食机的家长很久都不会清洗一次,有些甚至从来没洗过。

推荐指数:★★☆☆☆
清洗频率:3天/次,如主人不出远门,只放置当天的量。
同时,大量的猫粮长期放置在自动喂食机中。与密封储粮桶相比,更容易引起食品变质等安全问题。因此,我们应该更加注意定期清洁和消毒。一般来说,我们应该每三天更换一次。顺便说一句,我们应该换水和食物。但如果是多猫家庭,我相信铲粪官员不到三天就会发现上面漂浮着一层猫毛。
塑料碗:
由于色彩艳丽,价格便宜,轻便又不会打碎,深受许多家长的喜爱。但是塑料材质本身却是经不起啃咬的,用钢丝球洗的时候还会出现划痕,极易藏污纳垢。
推荐指数:★☆☆☆☆
清洗频率:1顿/次,讲卫生,勤清洗。

虽然听起来很麻烦,但我们可以从另一个角度思考,让小猫每天和自己一起吃饭,然后把小猫的碗放在一起洗,也可以培养猫定点吃饭的习惯。
主子脏不脏 全看铲屎官
俗话说“病从口入”,铲屎官们担心爱宠吃得好不好的同时,也要注意它们的卫生情况呀!想想你自己吃饭的碗,能不刷干净就吃下一顿吗?可别因为自己的懒惰让主子们受到伤害,到时候追悔莫及。

为了自己和孩子的健康,赶快行动起来。也请转发给身边的铲粪官提醒他们!
你的宠物碗多久没刷了?!欢迎在评论区留言~
图片及视频素材来源于网络,
版权归原作者所有。
如涉及侵权或对版权有所疑问,
请在推送下留言,我们会尽快处理。
◆◆END◆◆

